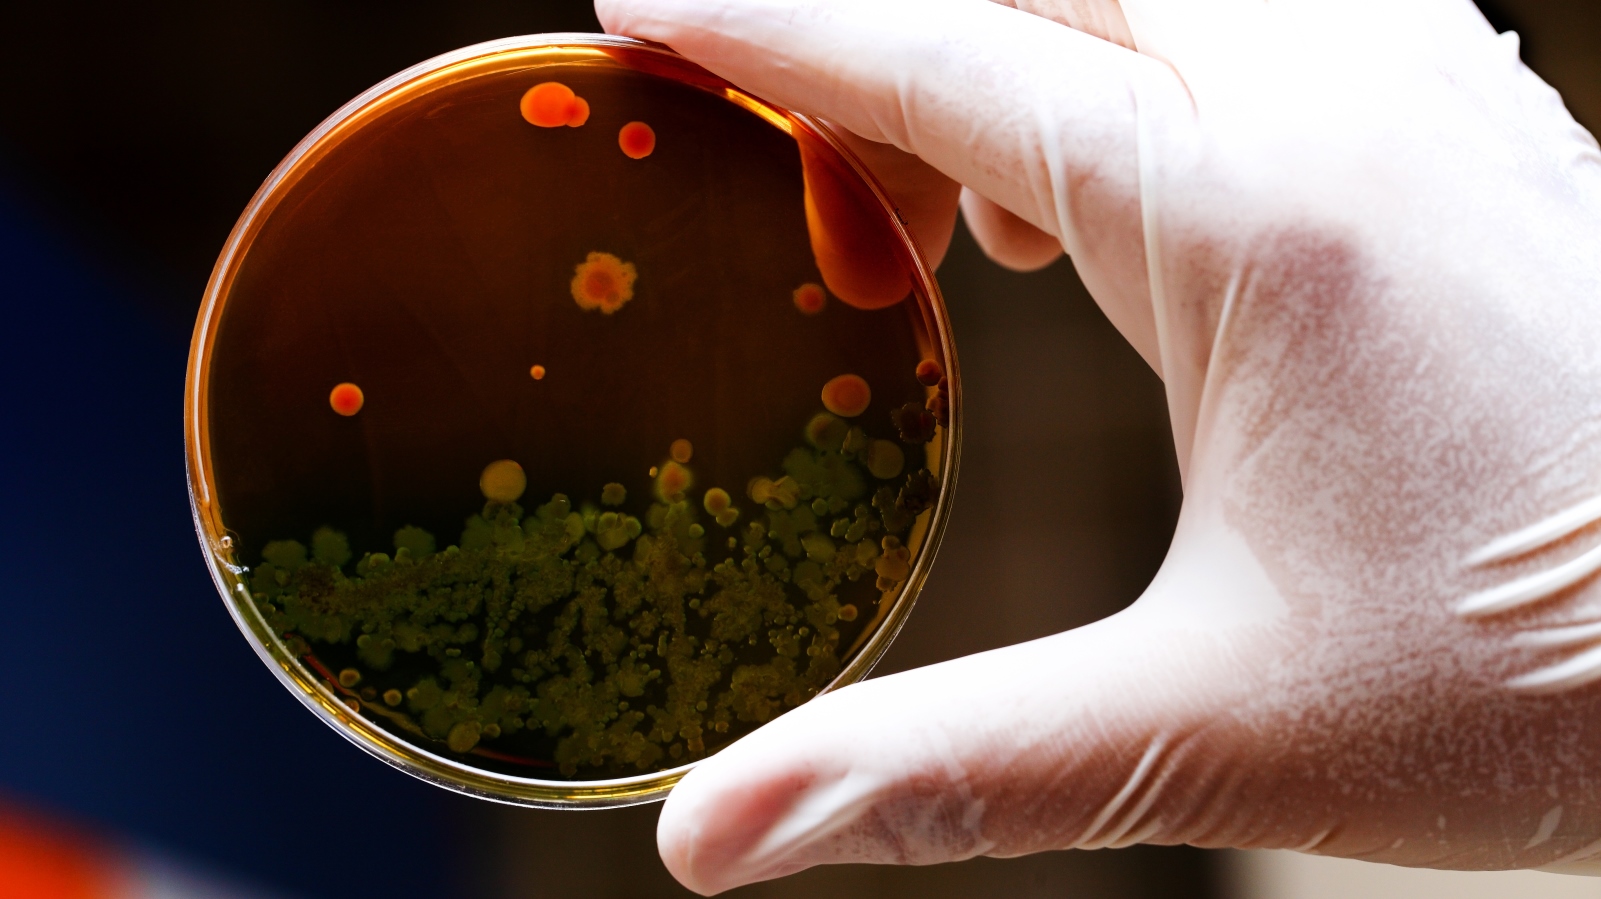

Team Prismatix – a collaboration between Prof. Ester Segal’s research group at the Technion-Israel Institute of Technology department of biotechnology and food engineering and clinicians from Bnai Zion Medical Center, also in Haifa – has won a Discovery Award for its promising developments in rapid diagnostics for antibiotic resistance.

Discovery Awards are seed grants to help teams and individuals further develop their ideas for the Longitude Prize, a challenge worth £10 million to help solve the problem of antibiotic resistance. The program is run by Nesta, the UK’s innovation foundation, with Innovate UK as funding partner.
Team Prismatix’s technology determines antibiotic resistance in less than three hours. Using minimal volumes, bacteria are grown on small photonic silicon chips.
Technion PhD student Heidi Leonard, who leads the research effort, explains that “By measuring how light reflects off the surface of these bio-chips, we can determine whether bacteria are growing or dying in the presence of certain antibiotics and specific antibiotic concentrations. Importantly, our results are in excellent agreement with existing laboratory techniques.”
The preliminary findings and concepts were recently published in the journal ACS Nano.
In Europe alone, it is estimated that more than four million people per year acquire hospital-associated infections. Determining the correct antibiotic for an infection in a timely manner is critical for the patient and to prevent the spread of antimicrobial resistance.
However, a typical laboratory workup procedure requires 24 hours to confirm the presence of bacteria, and another 24 to 36 hours to identify the correct antibiotic to use. During that time, incorrect antibiotics may be administered, which can facilitate the growth of resistant strains.
It is estimated that by the year 2050, antimicrobial resistance will be the cause of 10 million deaths per year worldwide, surpassing cancer to become the leading cause of death.
In addition to Leonard and Segal, Team Prismatix is comprised of Technion graduate Liran Holtzman; Dr. Ofer Nativ, chairman of urology at Bnai Zion; Dr. Sarel Halachmi, vice chairman of urology at Bnai Zion; and Prof. Leigh Canham from the University of Birmingham, England.